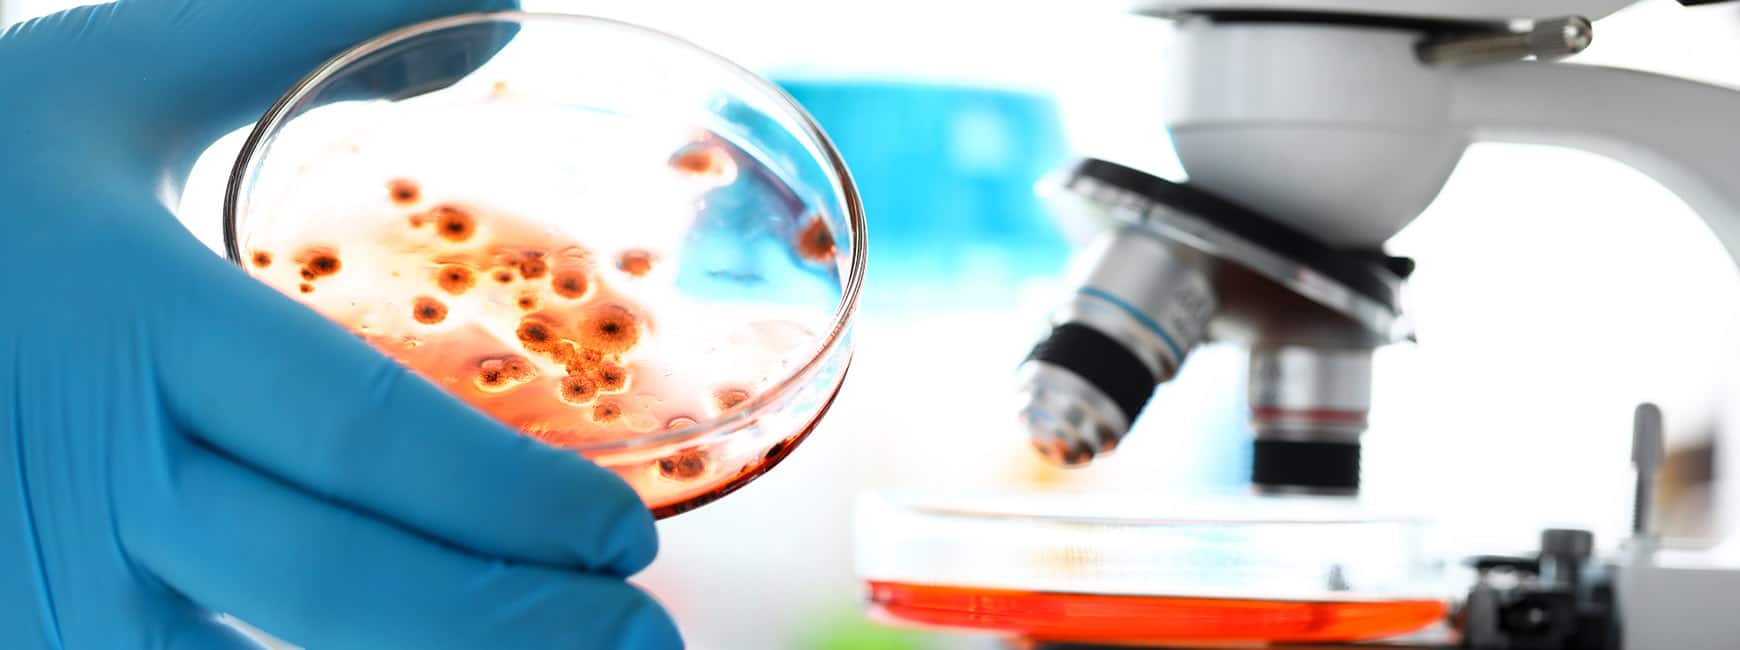
Vi tilbyder et bredt udvalg af test for både synlig og skjult skimmelsvamp. Med og uden laboratorieanalyser

Skimmelsvamp!
Er du en af de mange, der er blevet ramt af skimmelsvamp i dit hjem? Det kan du meget vel være, for skimmelsvamp vokser og trives rigtig godt i relativt fugtige indendørsmiljøer. Og fugt er desværre meget almindeligt i vores hjem.
Så hold øje med dit hjem. Hvis du bemærker grønne, sorte, brune eller hvide pletter eller mærker på vægge eller lofter et sted i dit hjem, bør du straks undersøge det.
Om AGX MögelTest /
AGX Nordic
AGX Nordic arbetar med att lösa problem med mögel och radon i Norden. AGX MögelTest erbjuder nya och prisvärda alternativ för mögeltestning och radontestning, så att du kan undvika hälsoproblem.
AGX Nordic är ett systerbolag till danska AGX Nordic ApS. Vårt huvudkontor och lager ligger i Glostrup, nära Köpenhamn i Danmark.
Vores udvalgte produkter
Se vores fulde udvalg-
Hurtig test for skimmelsvamp – PRO-Clean (min. 2 stk.)
Rabat ved køb af flere - ned til 70 DKK pr. stk. Test hurtigt for skimmelsvamp på synlige eller mistænkelige overflader. PRO-Clean er en nem enzymtest, der giver en indikation på kun få minutter.89,00 kr.Rabat ved køb af flere
Antal Pris pr. stk. 2-9 89 kr. 10-24 85 kr. 25-99 80 kr. 100+ 70 kr. Mængderabatten beregnes automatisk, når du vælger antal.
-
Den anbefalede radonmåling (min. 2 stk.)
Rabat ved køb af flere – ned til 270 DKK pr. stk. Sundhedsstyrelsen anbefaler radonmåling med passive målebokse, også kaldet radon dosimetre eller sporfilmsdosimetre. Hos AGX Nordic er mindstekøb 2 stk., fordi laboratoriet skal bruge mindst to målebokse for at kunne beregne en årsmiddelværdi. Returforsendelse til laboratoriet og analyserapport er inkluderet i prisen. Husk! Vi tilbyder gratis rådgivning og er eksperter i at nedbringe for høje radonniveauer med radonsug, radondræn og radonventilation.325,00 kr.Rabat ved køb af flere
Antal Pris pr. stk. 2 325 kr. 3-4 299 kr. 5-9 280 kr. 10+ 270 kr. Mængderabatten beregnes automatisk, når du vælger antal.
-
Tilbud
Tilbud
Skimmelsvamp lufttest
Test selv niveauet af skimmelsporer i luften. Vi anbefaler normalt to test: Én indendørs og én udendørs, så du kan sammenligne resultatet og få et bedre grundlag for vurderingen. NB! Testen bør anvendes hurtigst muligt efter modtagelse, da den har begrænset holdbarhed.Den oprindelige pris var: 299,00 kr..239,00 kr.Den aktuelle pris er: 239,00 kr.. -
Tilbud
Tilbud
Airthings Corentium Home (Canary) elektronisk radonmåler
Corentium Home fra Airthings byder bl.a. på enkel betjening. Radon-måleapparatet, der er et af de mest populære på markedet, giver dig mulighed for at følge med fra døgn til døgn, uge til uge, eller over hele måleperioden.Den oprindelige pris var: 1.390,00 kr..1.290,00 kr.Den aktuelle pris er: 1.290,00 kr.. -
Tilbud
Tilbud
DNA-analyse af støv
Tilbud. Avanceret DNA-test til undersøgelse af skjult skimmelsvamp i bygningen. Testen analyserer støv for skimmelsvamp-DNA og kan give en faglig indikation af, om der er tegn på skjult skimmelvækst. Prøven analyseres på laboratorium, og du modtager en rapport pr. e-mail.Den oprindelige pris var: 2.400,00 kr..1.990,00 kr.Den aktuelle pris er: 1.990,00 kr..